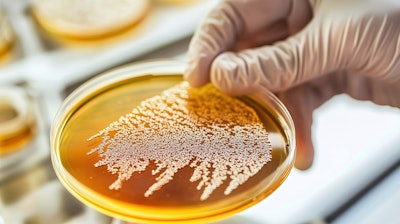
As precision fermentation advances, the scientific community will need to continue to overcome technical challenges for optimizing both the flavor and scalability of these products.

Precision fermentation is the new buzzword in the food industry. Like most innovations, it has its pros and cons. As a scientist, I believe any tool used for the right reason is good.
This article is only available to registered users.
Log In to View the Full Article
Precision fermentation is the new buzzword in the food industry. Like most innovations, it has its pros and cons. As a scientist, I believe any tool used for the right reason is good.
Over the past few decades, precision fermentation has been used to produce vaccines, hormones, enzymes, alternate protein sources and so much more. So, the question is, why not flavors?
With growing acceptance and applicability of precision fermentation in addressing problems of food security and sustainability, the flavor industry won’t be far behind in embracing targeted fermentation for the generation of flavor molecules. In fact, many flavor companies have already made strides in being self-reliant in this space, especially in the face of lower fruit yields due to disease and climate changes.
We can leverage this proven technology to meet market demand for clean label, all-natural products with complex flavor profiles that expand into diverse global menus. And we can do it all while respecting the environmental impact of sourcing those flavors using sustainable practices.
 Suja Senan, senior innovation scientist at Sensient Flavors & Extracts
Suja Senan, senior innovation scientist at Sensient Flavors & Extracts
What is precision fermentation?
To fully unpack precision fermentation, we should aim first to understand traditional fermentation.
Fermentation is a chemical process where molecules get broken down by yeasts and other microorganisms that grow in the absence of air. This transformation is common to sugars found in muscle, yeasts, some bacteria, and plants. This anaerobic process of fermentation also creates by-products (produces new molecules).
Throughout history, people have been exploiting microorganisms and their metabolic pathways for our benefit. We rely on the ability of bacterial and fungal cells to break down substrates and release compounds that affect flavor, color, texture, and functionality of the food.
Within traditional fermentation, the frontier has been the application of high throughput sequencing and multi-omic approaches to decode the complex mechanisms in flavor generation during fermentation. This has led to better selection of starter cultures and optimization of fermentation conditions to improve yield of desirable traits and reduce undesirable by-products.
But what about precision fermentation?
At its most basic level, precision fermentation is a tool to transform cells into cell factories that assemble “molecules of interest” (desirable products) at a faster rate, resulting in a purer form.
Where traditional fermentation relies on existing machinery of genes within the organism, precision fermentation is a targeted technology of using bacterial and fungal cells as factories to provide high titers of desirable compounds.
Precision fermentation uses metabolic engineering tools to create a chassis of carefully assembled genes of interest. The genes of interest produce compounds—like flavors—that have not historically been produced by the organism on its own.
For example, precision fermentation enabled a yeast to produce nootkatone, which comes from grapefruit. A deep dive into the biosynthesis of nootkatone led to the identification of key enzymes, the genes for which could be assembled into a yeast that could ferment sugar and release nootkatone molecules.
Regulatory issues and consumer perception
Transforming cells into cell factories involves some metabolic engineering that can blur the line between genetically modified and genetically edited strains. The regulatory landscape varies a bit from region to region, but as long as the product does not contain any remnants of the edited gene, it does not require any special labeling in the United States.
Fermentation is a natural process. While precision fermentation does use modified microorganisms to initiate the fermentation process, those edited genes are filtered out and removed at the end, leaving no trace before entering the mainstream food supply.
The approach to produce flavors using precision fermentation is not new and can be compared to the processes that develop insulin, rennet, Reb M or recombinant soybean hemoglobin. In fact, this process has been used for decades to create the rennet that makes cheese curds.
Genome sequencing for flavor innovation
Advancements in bacterial and yeast genome sequencing, coupled with computational tools, enable a deeper understanding of metabolic pathways leading to flavor molecules. The critical factor in the success of developing flavors via fermentation—traditional or precision—is understanding the genome and the calculated or precise modification of the biosynthetic pathway leading to high yield of flavor compounds.
Whole genome sequencing includes the isolation of DNA, breaking them into smaller base pairs and then adapter-ligated DNA fragments are amplified and sequenced. High-throughput technologies based on 16S ribosomal RNA (rRNA) gene-amplicon sequencing has come a long way in the last 30 years. Today, there are many available genomes in the public domain, and it does not take a lot of resources to get your strain of interest genome-sequenced at a service company.
Apart from knowing the sequence, it is equally important to understand their function. The comprehensive landscape of multiple omics is crucial to gain a comprehensive view of biological complexity in the generation of flavors.
A multi-omic approach to strain development
Multi-omics can include any combination of genomics, transcriptomics (RNA sequencing), proteomics (protein interactions) or metabolomics (biochemical responses).
To decode the entirety of flavor generation, we must see the entire process and not just snippets. Computational tools can be especially impactful in mapping metabolic pathways to optimize the production of specific flavor molecules.
For example, in addition to the genome sequencing tools and the other omic tools to establish meaningful connections between genotype and phenotype, the Clustered Regularly Interspaced
Fermentation optimization
Short Palindromic Repeat (CRISPR)-associated Cas9 nuclease system is another important tool in the precision fermentation toolbox.
After designing a high-performance strain, the next challenge lies in fermentation optimization and scale-up. In recent times, artificial neural networks (ANNs) have found application in predictive modeling of fermentation processes.
The advent of machine learning has accelerated the timeline for getting useful information to devise low-cost production systems and maximize safety of using engineered strains
Preserving flavor preservation
As precision fermentation advances, the scientific community will need to continue to overcome technical challenges for optimizing both the flavor and scalability of these products. One challenge in using precision fermentation in replicating traditional fermentation is how to capture the full flavor complexity in one compound.
For example, cocoa fermentation or tea fermentation and their end-flavor profiles are an interplay of the substrate, the environment and the microflora that are intentionally or unintentionally bringing about the biochemical breakdowns called fermentation.
With precision fermentation being more targeted, it may produce a lot of one compound rather than a balanced concoction of multiple compounds that define a flavor profile.
As precision fermentation advances, the scientific community will need to continue to overcome technical challenges for optimizing both the flavor and scalability of these products.Екатерина Чумаченко at Adobe Stock
As precision fermentation advances, the scientific community will need to continue to overcome technical challenges for optimizing both the flavor and scalability of these products.Екатерина Чумаченко at Adobe Stock
Scaling precision fermentation
In terms of scalability, the designing of the strain is a big milestone, followed by optimization of the titer values in the fermenter. Based on the nature of the flavor compound, it may need a skid of multiple downstream processing units, like centrifuge and filtration columns, to end up with a pure compound.
There is a growing trend for companies to share production facilities or co-manufacturing sites as well as to rent equipment to optimize their process before investing in those in-house infrastructures.
Precision fermentation & the clean, sustainable food movement
Precision fermentation is working to change the food creation landscape. Scientists are already producing yeast extracts and peptones to support biomass, metabolite yields and strain recovery for industries like probiotics, food cultures, enzymes and alcohol. We are now leveraging those technologies to create distinctive flavors that meet the growing consumer demand for clean label and sustainable foods.
Fermented flavors align with consumers’ desire for natural, clean, traditional and global tastes, offering functional and sustainable benefits. This new processing technique also helps solve ongoing pervasive issues with supply chain, sourcing ingredients and food insecurity. For example, fermented flavors have always triggered sentiments of “good for you,” “clean” and “close to nature.”
However, fermented products like miso, kimchi, natto, kefir and others take months to mature and develop their decadent flavors. Additionally, sourcing the right ingredients is the cornerstone of these products that are gaining a lot of momentum in a generation looking for exciting and culturally diverse flavors.
Unique blends of fermented koji with other ingredients in cocktails and on culinary menus speak to the trend of fermented flavors that embrace richness and a complex cascade of flavors. But how many of us can travel to savor these flavors, and how can we protect the unique flavor profiles of coffee, cocoa or tea that are fermented like an art?
This is where precision fermentation can help generate almost identical flavors using simple sugars and metabolically engineered yeasts in a simple fermenter without using protected lands or overconsuming in-demand plants. With precision fermentation, we can create nootkatone without grapefruit, vanilla without beans, and so on.
Precision fermentation can be the solution for getting novel compounds in high titers, in pure form, produced at large scale without needing to farm large arable lands or rely on trees susceptible to extinction, diseases or seasonal variabilities. At the same time, precision fermentation works on the premise that using designed strains can grow less expensive substrates, lowering costs while minimizing waste and environmental impact.










